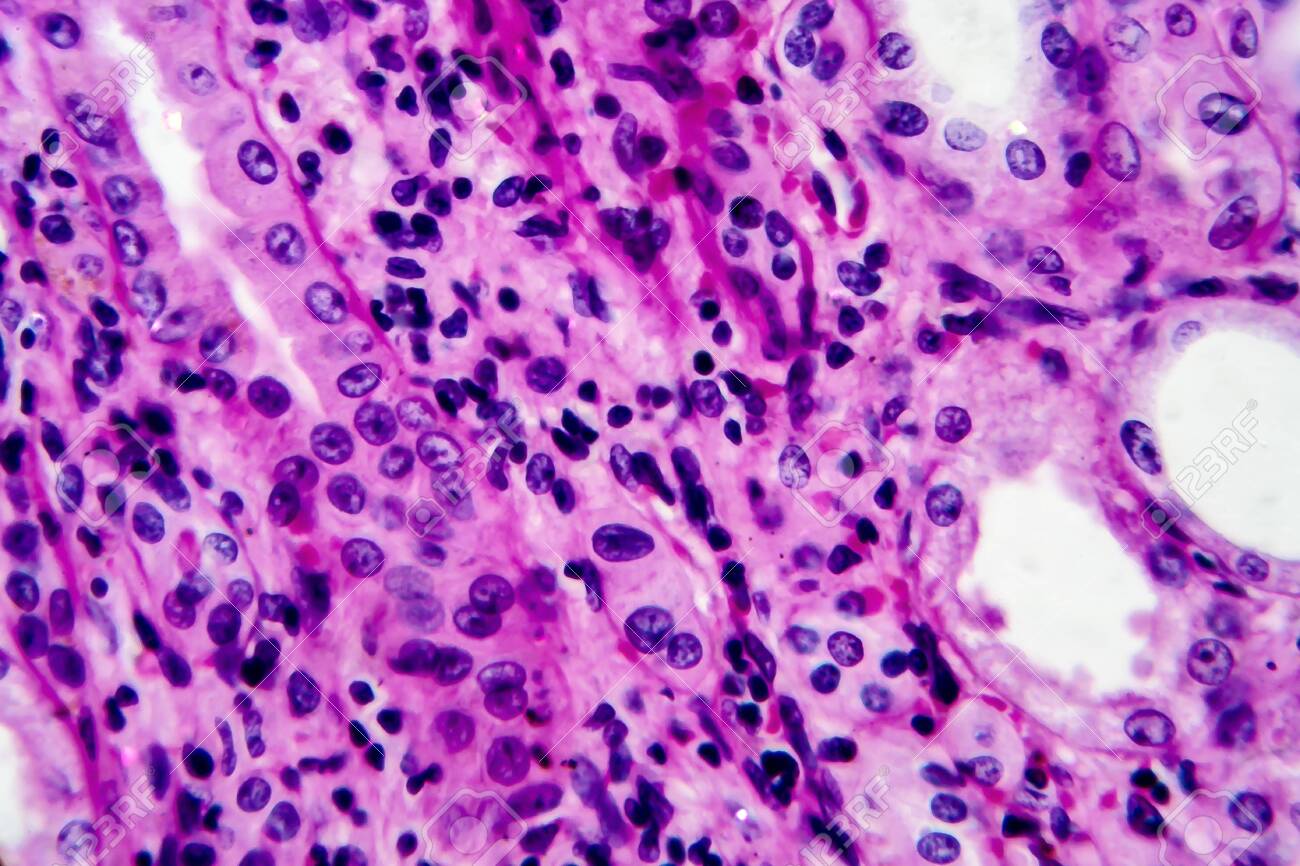
etiam-dictum-ipsum-a-felis

Download
Close
Автор:
id:
Ключевые слова:
cell, chronic, closeup, disease, eosin, genitourinary, hematoxylin, high, histology, histopathology, illness, infection, inflammation, kidney, magnification, medical, medicine, micro, micrograph, microphotograph, microscope, microscopic, microscopy, morphological, morphology, nephritis, pathology, photomicrograph, pyelonephritis, renal, stain, tissue, urinary,





